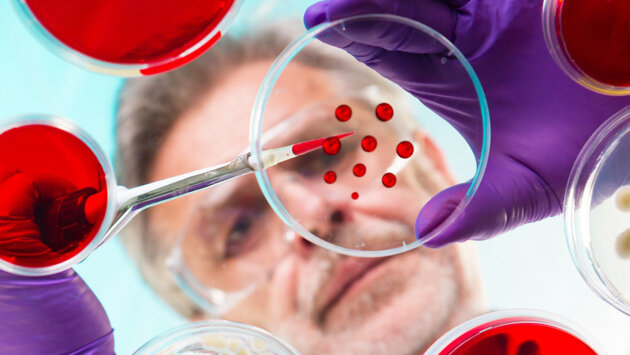

Врачи заявили о вреде анализа на онкомаркеры для здоровья
Настоящая бомба взорвалась на конференции Европейского общества медицинской онкологии (ESMO). Доктор Крэйг Баррингтон из Ракового центра Юго-Западного Уэльса заявил, что онкомаркеры, которые сегодня предлагают для раннего выявления рака, практически не эффективны. Мало того, что они дороги, но и вызывают у пациентов необоснованную панику.
Конечно, это заявление ученого стало сенсацией. Ведь врачи всего мира озабочены, как на самой ранней стадии распознать рак. Если удается, то почти всегда его можно вылечить быстро и дешево. Однако коварство этой болезни в том, что именно на ранних стадиях он почти незаметен. Поэтому онкомаркеры, которые могут указывать на онкологические процессы в организме, считаются одним из самых эффективных тестов на ранний рак. Во всяком случае, именно такая у них сложилась репутация, а многие медицинские центры предлагают пройти подобные исследования.
И вот Крэйг Баррингтон, говоря образно, замахнулся на "святое". Отметим, что он провел основательное исследование, охватив большие группы пациентов. Ученый изучил почти 1747 назначений на онкомаркеры, которые были сделаны терапевтами и онкологами. Результаты, прямо скажем, поражают. Из 1747 тестов рак, в конце концов, нашли у 297 человек (17 процентов), но самое главное, что именно онкомаркеры указали на этот диагноз всего в 35 случаях (2 процента). Если более конкретно, то после назначения на тест терапевтами диагноз "рак" был поставлен 50 из 985 пациентов, причем онкомаркер сразу указал на этот диагноз всего в пяти случаях (0,5 процента). Что касается 762 назначений онкологов, то рак по итогам всех исследований диагностирован у 244 пациентов (32 процента), и только у 30 из них - при помощи теста на онкомаркеры.
Ранней диагностики вы не получите, а нервотрепка на пустом месте вполне реальна
- Большая часть анализов на онкомаркеры не выявила злокачественной опухоли, - сказал Баррингтон на конференции. - А когда у пациентов все-таки нашли рак, в большинстве случаев маркеры не внесли вклада в диагностику заболевания.
Баррингтон подчеркивает, что помимо высокой стоимости таких тестов, они вызывают у пациентов серьезное беспокойство, приводят к назначению дополнительных анализов, которые тоже далеко не всегда помогают поставить верный диагноз.
Комментарий
Давид Заридзе, член-корреспондент РАН, президент Противоракового общества России:
Ни один онкомаркер для скрининга рака, его выявления на ранней стадии нигде никогда не использовался. Во всяком cлучае официальной такой рекомендации ни в одной стране Запада, ни в России нет. Особый разговор - маркер ПСА, который многие годы применялся для выявления на ранней стадии рака предстательной железы. Но сейчас он признан не только неэффективным, но и вредным в большинстве стран. В США большинство профессиональных медицинских ассоциаций рекомендовали отказаться от массового ПСА-тестирования. Опыт показал, что оно часто становится причиной гипердиагностики, то есть диагноза рака там, где его нет, а соответственно, ненужного, а иногда и чрезмерного лечения. По американским данным, в стране за последние пару десятков лет проведено более миллиона ненужных операций, включая удаление простаты.
Когда имеет смысл применять онкомаркеры? Только для мониторинга в клинике, когда опухоль уже обнаружена. У такого больного высокий показатель соответствующего маркера. Он сильно снижается, когда опухоль удаляют. После операции за онкомаркером постоянно следят. И если он вдруг начинает расти, то значит, где-то появились метастазы. Вот здесь маркер четко выполняет свою функцию: мониторинг перед лечением и после. А когда разные коммерческие центры за большие деньги предлагают провести анализ на онкомаркеры, могу только призвать, не выбрасывайте деньги не ветер. Никакой ранней диагностики вы не получите. А вот нервотрепка на пустом месте вполне реальны.